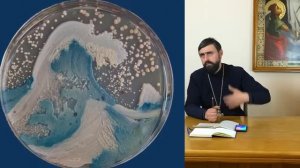
МОЖНО ЛИ ЗАРАЗИТЬСЯ В ЦЕРКВИ? МИКРОБИОЛОГИЯ ХРАМА. Прот. Александр Проченко

1:26:13
1:26:13
2023-09-07 18:34

 37:45
37:45

 37:45
37:45
2023-12-05 08:21

 1:57:04
1:57:04

 1:57:04
1:57:04
2023-11-15 15:55

 24:12
24:12

 24:12
24:12
2022-03-03 22:16

 59:60
59:60

 59:60
59:60
2023-09-27 10:54

 1:44:05
1:44:05
1:44:05
1:44:05
2023-07-09 13:05

 17:15
17:15

 17:15
17:15
2023-02-19 12:14

 5:07
5:07

 5:07
5:07
2023-08-31 12:53

 9:25
9:25

 9:25
9:25
2021-08-06 15:40

 4:47
4:47

 4:47
4:47
2023-08-30 10:21

 2:23:45
2:23:45

 2:23:45
2:23:45
2026-01-25 23:55

 10:25:31
10:25:31

 10:25:31
10:25:31
2025-05-02 07:58

 3:12:39
3:12:39

 3:12:39
3:12:39
2023-09-15 21:20

 11:56:60
11:56:60

 11:56:60
11:56:60
2025-08-29 07:40

 5:36
5:36

 5:36
5:36
2026-01-15 01:44

 2:58:11
2:58:11

 2:58:11
2:58:11
2023-12-21 11:53

 2:32:19
2:32:19

 2:32:19
2:32:19
2023-09-10 18:25

 2:13:04
2:13:04
![Syuzi Dzhaginian - Сегодня я плачу (Премьера клипа 2026)]() 2:57
2:57
![Ирина Круг и Вика Ветер - Крестик (Премьера клипа 2026)]() 3:53
3:53
![Рустам Батербиев - Стерва-ночь (Премьера клипа 2026)]() 2:24
2:24
![Вусал Мирзаев - Ты моя (Премьера клипа 2026)]() 2:14
2:14
![Ислам Итляшев - Боинг (Премьера клипа 2026)]() 2:42
2:42
![Алишер Файз - Биё-биё (Премьера клипа 2026)]() 3:16
3:16
![Jazzdauren - Юность (Премьера клипа 2026)]() 2:44
2:44
![Кравц - 99 проблем (Премьера клипа 2026)]() 2:30
2:30
![Cvetocek7 - Молния (Премьера клипа 2026)]() 2:41
2:41
![Медина Мелик - Дура (Премьера клипа 2026)]() 2:41
2:41
![Сарвар Мадримов - Бора-бора (Премьера клипа 2026)]() 3:09
3:09
![Андрей Храмов - Я приглашу тебя на танец (Премьера клипа 2026)]() 4:01
4:01
![Elvira T - Don't Cry (Премьера клипа 2026)]() 3:27
3:27
![Шавкат Зулфикор - Жигарлар (Премьера клипа 2026)]() 5:53
5:53
![ANIVAR - Маски (Премьера клипа 2026)]() 2:13
2:13
![Григорий Герасимов - Я другой (Премьера клипа 2026)]() 3:32
3:32
![Артур Бесаев - Там где горы (Премьера клипа 2026)]() 2:15
2:15
![Зироатхон - Бевафо (Премьера клипа 2026)]() 3:15
3:15
![Гунеша - Юр кетамиз (Премьера клипа 2026)]() 3:13
3:13
![Евгений Григорьев ЖЕКА, Алёна Егорова - Синхронит любовь (Премьера клипа 2026)]() 3:24
3:24
![Бугония | Bugonia (2025)]() 1:59:12
1:59:12
![Голубая луна | Blue Moon (2025)]() 1:40:33
1:40:33
![Пойман с поличным | Caught Stealing (2025)]() 1:46:45
1:46:45
![Лакомый кусок | The Rip (2026)]() 1:52:50
1:52:50
![Игры Биста. 2 сезон, 4 серия | Beast Games 2 season]() 1:01:10
1:01:10
![Побег из плена | Prisoner of War (2025)]() 1:52:58
1:52:58
![Гарри Поттер и Орден Феникса | Harry Potter and the Order of the Phoenix (2007)]() 2:18:19
2:18:19
![Мерв | Merv (2025)]() 1:46:56
1:46:56
![Супергеройское кино | Superhero Movie (2008)]() 1:22:33
1:22:33
![Сожалею о тебе | Regretting You (2025)]() 1:55:53
1:55:53
![Всемирный потоп | Daehongsu (2025)]() 1:48:57
1:48:57
![Злая. Часть 2 | Wicked: For Good (2025)]() 2:17:37
2:17:37
![Гарри Поттер и узник Азкабана | Harry Potter and the Prisoner of Azkaban (2004)]() 2:21:46
2:21:46
![Пять ночей с Фредди 2 | Five Nights at Freddy's 2 (2025)]() 1:44:11
1:44:11
![Гарри Поттер и Дары Смерти: Часть II | Harry Potter and the Deathly Hallows - Part 2 (2011)]() 2:10:30
2:10:30
![Игры Биста. 2 сезон, 5 серия | Beast Games 2 season]() 49:20
49:20
![Бегущий человек | The Running Man (2025)]() 2:16:29
2:16:29
![Зверополис 2 | Zootopia 2 (2025)]() 1:47:36
1:47:36
![Очень голодные игры | The Starving Games (2013)]() 1:18:55
1:18:55
![Доверие | Trust (2025)]() 1:30:44
1:30:44
![Команда Дино Сезон 1]() 12:08
12:08
![Мультфильмы военных лет | Специальный проект к 80-летию Победы]() 7:20
7:20
![Мотофайтеры]() 13:10
13:10
![МегаМен: Полный заряд Сезон 1]() 10:42
10:42
![Сборники «Умка»]() 3:09:60
3:09:60
![Папа Супергерой Сезон 1]() 4:28
4:28
![Поймай Тинипин! Королевство эмоций]() 12:24
12:24
![Пип и Альба. Приключения в Соленой Бухте! Сезон 1]() 11:02
11:02
![Пип и Альба Сезон 1]() 11:02
11:02
![Простоквашино. Финансовая грамотность]() 3:27
3:27
![Чуч-Мяуч]() 7:04
7:04
![Сборники «Оранжевая корова»]() 1:05:01
1:05:01
![Богатырята]() 11:00
11:00
![Отважные мишки]() 13:00
13:00
![Синдбад и семь галактик Сезон 1]() 10:23
10:23
![Роботы-пожарные]() 12:31
12:31
![Школьный автобус Гордон]() 12:34
12:34
![Корги по имени Моко. Волшебный мир снов]() 8:60
8:60
![Отряд А. Игрушки-спасатели]() 13:06
13:06
![Карли – искательница приключений. Древнее королевство]() 13:00
13:00

 2:13:04
2:13:04Скачать Видео с Рутуба / RuTube
| 240x240 | ||
| 360x360 | ||
| 480x480 | ||
| 720x720 |
 2:57
2:57
2026-01-28 11:50
 3:53
3:53
2026-01-23 18:04
 2:24
2:24
2026-01-15 13:21
 2:14
2:14
2026-01-15 12:40
 2:42
2:42
2026-01-20 01:15
 3:16
3:16
2026-01-28 11:55
 2:44
2:44
2026-01-28 11:45
 2:30
2:30
2026-01-14 15:04
 2:41
2:41
2026-01-16 16:41
 2:41
2:41
2026-01-13 10:54
 3:09
3:09
2026-01-14 15:26
 4:01
4:01
2026-01-15 13:30
 3:27
3:27
2026-01-08 12:19
 5:53
5:53
2026-01-10 14:39
 2:13
2:13
2026-01-10 14:36
 3:32
3:32
2026-01-14 15:22
 2:15
2:15
2026-01-16 16:50
 3:15
3:15
2026-01-28 12:20
 3:13
3:13
2026-01-12 10:24
 3:24
3:24
2026-01-15 12:53
0/0
 1:59:12
1:59:12
2025-11-29 02:45
 1:40:33
1:40:33
2025-12-17 23:52
 1:46:45
1:46:45
2026-01-19 12:39
 1:52:50
1:52:50
2026-01-23 09:26
 1:01:10
1:01:10
2026-01-15 03:46
 1:52:58
1:52:58
2026-01-26 14:34
 2:18:19
2:18:19
2025-12-25 15:40
 1:46:56
1:46:56
2025-12-12 13:56
 1:22:33
1:22:33
2025-11-21 14:16
 1:55:53
1:55:53
2025-12-17 23:52
 1:48:57
1:48:57
2026-01-14 15:48
 2:17:37
2:17:37
2026-01-14 15:48
 2:21:46
2:21:46
2025-12-25 15:40
 1:44:11
1:44:11
2025-12-25 22:29
 2:10:30
2:10:30
2025-12-25 15:40
 49:20
49:20
2026-01-23 13:36
 2:16:29
2:16:29
2025-12-17 23:52
 1:47:36
1:47:36
2025-12-25 17:49
 1:18:55
1:18:55
2025-11-21 14:16
 1:30:44
1:30:44
2025-12-17 23:52
0/0
2021-09-22 22:29
 7:20
7:20
2025-05-03 12:34
 13:10
13:10
2024-11-27 14:57
2021-09-22 21:43
 3:09:60
3:09:60
2025-12-11 18:53
2021-09-22 21:52
 12:24
12:24
2024-11-27 13:24
2021-09-22 23:36
2021-09-22 23:37
 3:27
3:27
2024-12-07 11:00
 7:04
7:04
2022-03-29 15:20
 1:05:01
1:05:01
2025-12-12 12:24
2026-01-12 13:08
 13:00
13:00
2024-11-29 13:39
2021-09-22 23:09
2021-09-23 00:12
 12:34
12:34
2024-12-02 14:42
 8:60
8:60
2025-12-09 11:58
 13:06
13:06
2024-11-28 16:30
 13:00
13:00
2024-11-28 16:19
0/0

